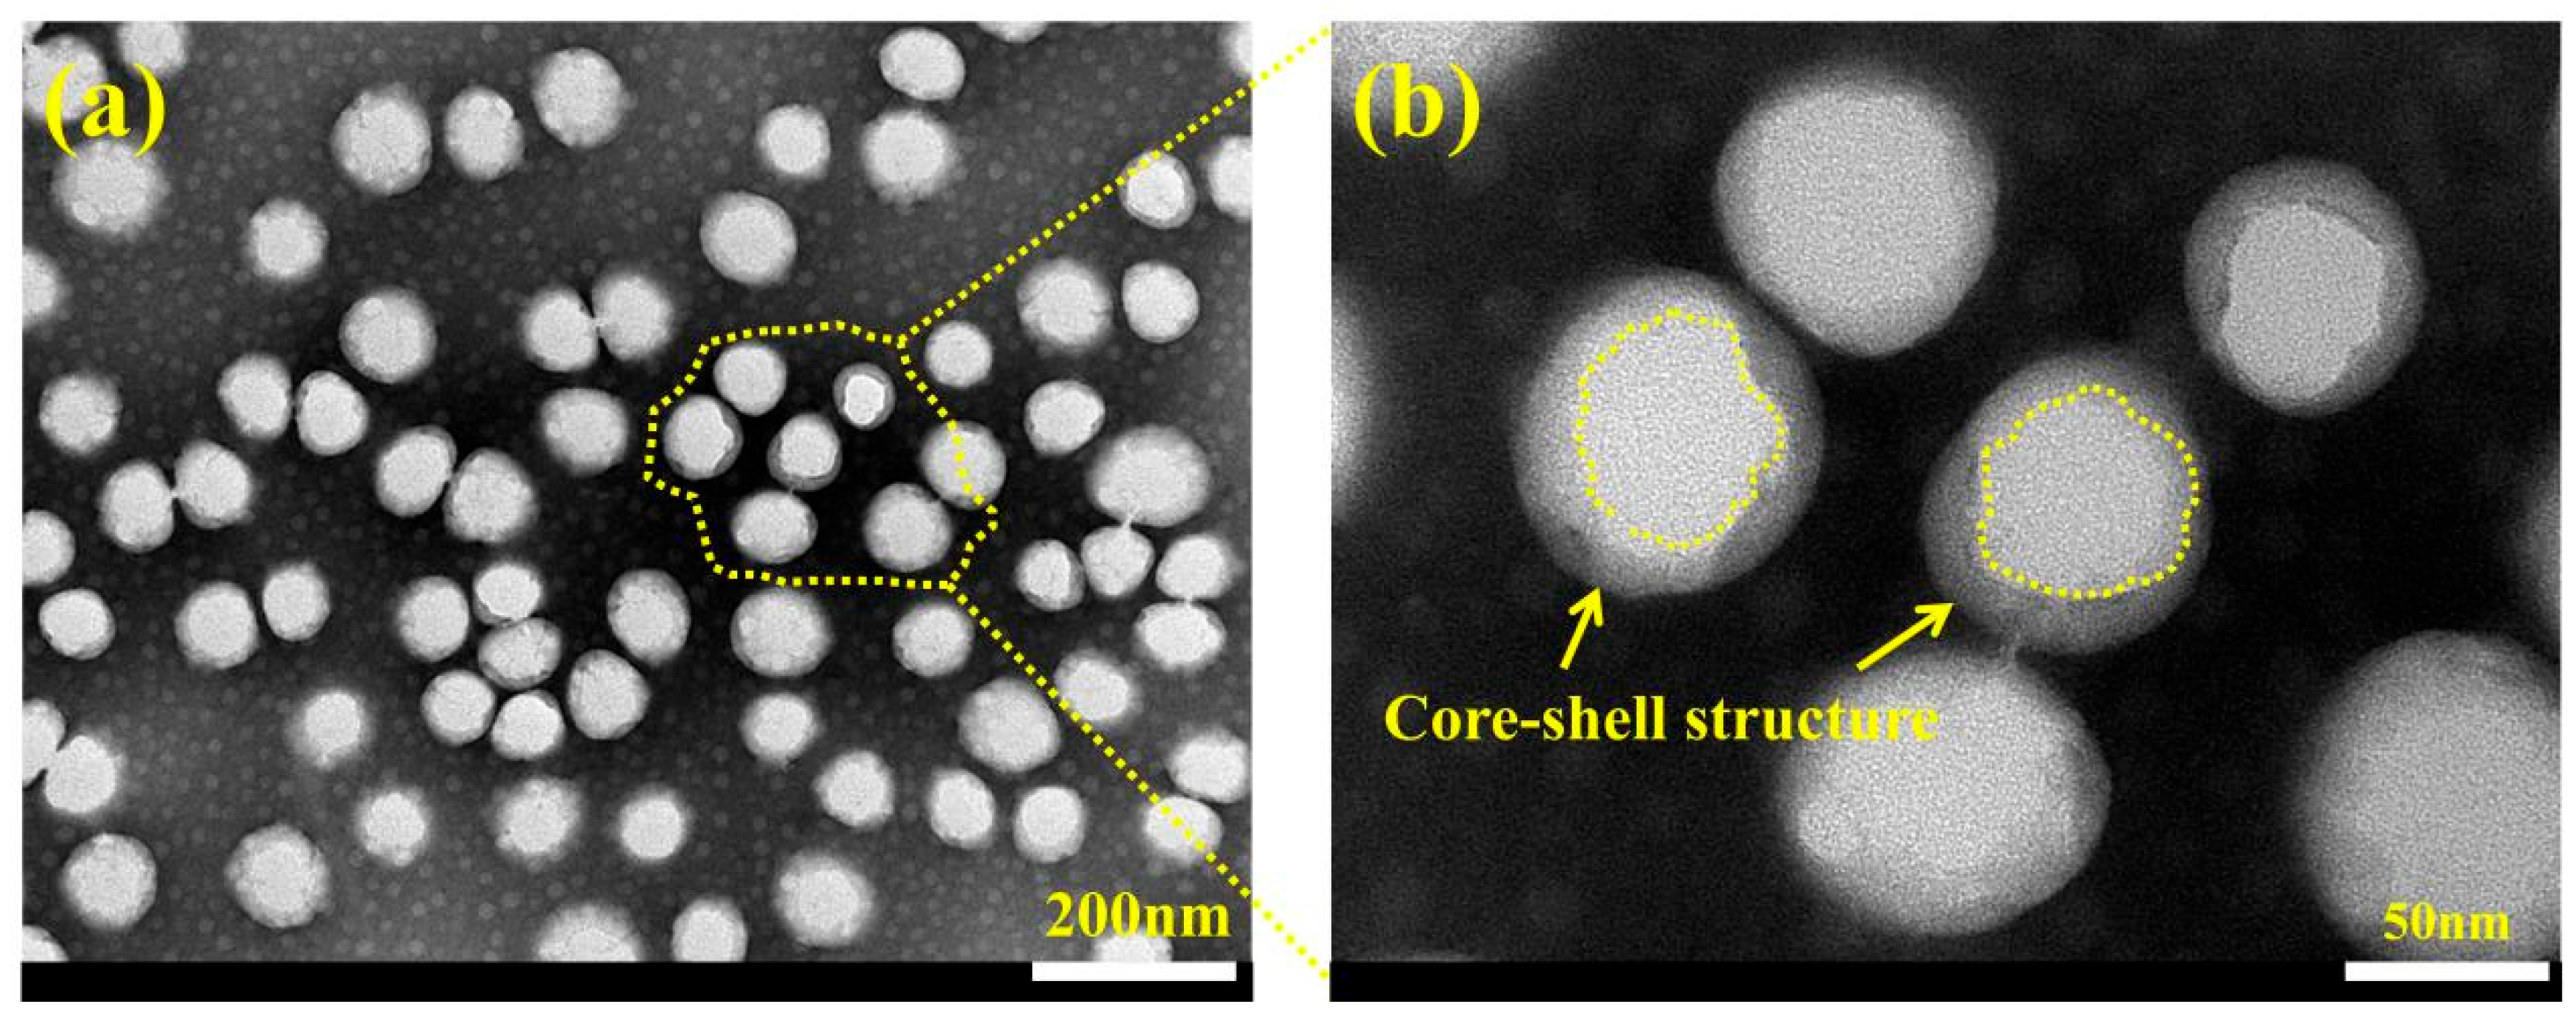
Coatings 15 00623 g004

Preparation and Corrosion Resistance Research of Eco-Friendly Strong Penetration Sealant for Fe-Based Amorphous Coatings
Abstract
1. Introduction
2. Experimental Procedure
2.1. Experimental Material
2.2. Preparation of Fe-Based Amorphous Coating
2.3. Preparation of Graphene Modified Waterborne Acrylic Sealant
2.3.1. Preparation of GO@SiO2
2.3.2. Preparation of Graphene Modified Waterborne Acrylic Sealant (WFS)
2.3.3. Detailed Sealing Process of Fe-Based Amorphous Coating
2.4. Characterization
3. Results and Discussion
3.1. Fe-Based Amorphous Coating Characterization
3.2. Natural Properties of WFE and WFS
3.3. Characterization of Morphology and Microstructure of WFE and GO@SiO2
3.4. Research on the Sealing Performance of WFS
3.5. Research on Corrosion Resistance of the Sealed Coating
4. Conclusions
- An eco-friendly graphene modified waterborne acrylic sealant (WFS) for sealing Fe-based amorphous coatings was successfully prepared. The sealant has good film-forming properties and excellent heat resistance, which ensures the stable quality of the hybrid sealant during service.
- The combination of ultrasonic immersion and vacuum sealing can effectively promote the penetration of the hybrid sealant into coating defects and form a three-dimensional radial network sealing structure, which significantly improves the compactness of the coating. The 3D scanning technology showed that the penetration depth of the hybrid sealant reached 160 μm.
- GO@SiO2 can significantly improve the cohesion strength of Fe-based amorphous coatings and increase the adhesion at the coating/substrate interface. With the addition of GO@SiO2, the pinhole phenomenon on the surface was significantly reduced.
- Nano-reinforced material was prepared to improve the long-term corrosion resistance of hybrid sealant. The polarization curves show that with the increase of GO@SiO2, the corrosion current density (icorr) and the maintain passive current density (ip) of the sealed samples decrease by an order of magnitude. After immersion for 672 h, the Rct values of samples WFS-1‰ (2104 Ω cm2) and WFS-3‰ (2982 Ω cm2) increased by more than one order of magnitude compared with 0# (131 Ω cm2). Hybrid sealant can effectively slow down the migration process of chloride ions for more than 28 days.
Supplementary Materials
Author Contributions
Funding
Institutional Review Board Statement
Informed Consent Statement
Data Availability Statement
Conflicts of Interest
References
- Li, G.; Gan, Y.; Liu, C.; Shi, Y.; Zhao, Y.; Kou, S. Corrosion and Wear Resistance of Fe-Based Amorphous Coatings. Coatings 2020, 10, 73. [Google Scholar] [CrossRef]
- Liu, M.M.; Hu, H.X.; Zheng, Y.G. Effects of three sealing methods of aluminum phosphate sealant on corrosion resistance of the Fe-based amorphous coating. Surf. Coat. Technol. 2017, 309, 579–589. [Google Scholar] [CrossRef]
- Wang, M.; Zhou, Z.; Wang, Q.; Wu, L.; Zhang, X. Long term semiconducting and passive film properties of a novel dense FeCrMoCBY amorphous coating by atmospheric plasma spraying. Appl. Surf. Sci. 2019, 495, 143600. [Google Scholar] [CrossRef]
- Wang, Y.; Jiang, S.L.; Zheng, Y.G.; Ke, W.; Sun, W.H.; Wang, J.Q. Electrochemical behaviour of Fe-based metallic glasses in acidic and neutral solutions. Corros. Sci. 2012, 63, 159–173. [Google Scholar] [CrossRef]
- Zhang, S.D.; Wu, J.; Qi, W.B.; Wang, J.Q. Effect of porosity defects on the long-term corrosion behaviour of Fe-based amorphous alloy coated mild steel. Corros. Sci. 2016, 110, 57–70. [Google Scholar] [CrossRef]
- Zhang, J.; Wang, Z.; Lin, P.; Si, L.; Shen, G.; Zhou, Z.; Jiang, S.; Lu, W. Corrosion of plasma sprayed NiCrAl/Al2O3–13 wt-% TiO2 coatings with and without sealing. Surf. Eng. 2012, 28, 345–350. [Google Scholar] [CrossRef]
- Shankar, A.R.; Mudali, U.K. Laser surface modification of plasma sprayed yttria stabilised zirconia coatings on type 316L stainless steel. Surf. Eng. 2009, 25, 241–248. [Google Scholar] [CrossRef]
- Xie, G.; Lin, X.; Wang, K.; Mo, X.; Zhang, D.; Lin, P. Corrosion characteristics of plasma-sprayed Ni-coated WC coatings comparison with different post-treatment. Corros. Sci. 2007, 49, 662–671. [Google Scholar] [CrossRef]
- Parhizkar, N.; Ramezanzadeh, B.; Shahrabi, T. Corrosion protection and adhesion properties of the epoxy coating applied on the steel substrate pre-treated by a sol-gel based silane coating filled with amino and isocyanate silane functionalized graphene oxide nanosheets. Appl. Surf. Sci. 2018, 439, 45–59. [Google Scholar] [CrossRef]
- Wang, G.; Zhou, Z.; Zhang, X.; Zhang, K.; Wu, L.; Yang, G. Synthesis of novel waterborne silicone modified acrylic sealant and its corrosion resistance in Fe-based amorphous coatings. Prog. Org. Coat. 2022, 170, 106950. [Google Scholar] [CrossRef]
- Dong, Q.; Ba, Z.; Jia, Y.; Chen, Y.; Lv, X.; Zhang, X.; Wang, Z. Effect of solution concentration on sealing treatment of Mg-Al hydrotalcite film on AZ91D Mg alloy. J. Magnes. Alloys 2017, 5, 320–325. [Google Scholar] [CrossRef]
- Ivanou, D.K.; Yasakau, K.A.; Kallip, S.; Lisenkov, A.D.; Starykevich, M.; Lamaka, S.V.; Ferreira, M.G.S.; Zheludkevich, M.L. Active corrosion protection coating for a ZE41 magnesium alloy created by combining PEO and sol-gel techniques. RSC Adv. 2016, 6, 12553–12560. [Google Scholar] [CrossRef]
- Zhang, J.; Wang, Z.; Lin, P.; Lu, W.; Zhou, Z.; Jiang, S. Effect of Sealing Treatment on Corrosion Resistance of Plasma-Sprayed NiCrAl/Cr2O3-8wt.%TiO2 Coating. J. Therm. Spray Technol. 2011, 20, 508–513. [Google Scholar] [CrossRef]
- Zhang, Y.; Wang, Z.; Shi, Y.; Shao, Y.; Gu, C. Combined effect of heat treatment and sealing on the corrosion resistance of reactive plasma sprayed TiNx/TiOy coatings. Ceram. Int. 2019, 45, 24545–24553. [Google Scholar] [CrossRef]
- Liu, M.; Wang, Z.; Hu, H.; Zhang, L.; Zheng, Y. Effect of Sealing Treatments on Erosion–Corrosion of a Fe-Based Amorphous Metallic Coating in 3.5 wt.% NaCl Solution with 2 wt.% Sand. Metals 2022, 12, 680. [Google Scholar] [CrossRef]
- Arun, S.; Sooraj, P.N.; Hariprasad, S.; Arunnellaiappan, T.; Rameshbabu, N. Fabrication of superhydrophobic coating on PEO treated zirconium samples and its corrosion resistance. Mater. Today Proc. 2020, 27, 2056–2060. [Google Scholar] [CrossRef]
- Zhang, J.; Wang, Z.; Lin, P. Effects of sealing on corrosion behaviour of plasma-sprayed Cr2O3–8TiO2 coating. Surf. Eng. 2013, 29, 594–599. [Google Scholar] [CrossRef]
- Novoselov, K.S.; Fal, V.I.; Colombo, L.; Gellert, P.R.; Schwab, M.G.; Kim, K. A roadmap for graphene. Nature 2012, 490, 192–200. [Google Scholar] [CrossRef]
- Lee, Y.; Ahn, J.H. Graphene-Based Transparent Conductive Films (vol 8, 1330001, 2013). Nano 2015, 10, 1592001. [Google Scholar] [CrossRef]
- Li, Y.; Huang, Y.; Wang, F.; Liang, W.; Yang, H.; Wu, D. Fabrication of acrylic acid modified graphene oxide (AGO)/acrylate composites and their synergistic mechanisms of anticorrosion and antifouling properties. Prog. Org. Coat. 2022, 168, 106910. [Google Scholar] [CrossRef]
- Zhou, S.; Wu, Y.; Zhao, W.; Yu, J.; Jiang, F.; Ma, L. Comparative corrosion resistance of graphene sheets with different structures in waterborne epoxy coatings. Colloids Surf. A Physicochem. Eng. Asp. 2018, 556, 273–283. [Google Scholar] [CrossRef]
- Wang, G.; Zhou, Z.; Hu, Q.; Shi, X.; Zhang, X.; Zhang, K.; Wu, L. Preparation of eco-friendly natural rosin-based SiO2–NH2@GO hybrid sealant and study on corrosion resistance of Fe-based amorphous coating for steel substrate. Carbon 2023, 201, 170–188. [Google Scholar] [CrossRef]
- Selim, M.S.; El-Safty, S.A.; Fatthallah, N.A.; Shenashen, M.A. Silicone/graphene oxide sheet-alumina nanorod ternary composite for superhydrophobic antifouling coating. Prog. Org. Coat. 2018, 121, 160–172. [Google Scholar] [CrossRef]
- Guo, S.-Y.; Luo, H.-H.; Tan, Z.; Chen, J.-Z.; Zhang, L.; Ren, J. Impermeability and interfacial bonding strength of TiO2-graphene modified epoxy resin coated OPC concrete. Prog. Org. Coat. 2021, 151, 106029. [Google Scholar] [CrossRef]
- Othman, N.H.; Yahya, W.Z.N.; Ismail, M.C.; Mustapha, M. Highly dispersed graphene oxide–zinc oxide nanohybrids in epoxy coating with improved water barrier properties and corrosion resistance. J. Coat. Technol. Res. 2020, 17, 101–114. [Google Scholar] [CrossRef]
- Guerrero-Bermea, C.; Vazquez-Rodriguez, S.; Sanchez-Valdes, S.; Uribe-Calderon, J.A. Synthesis of montmorillonite/modified graphene oxide filler and its effect on the properties of PP composites. Polym. Bull. 2021, 78, 3443–3457. [Google Scholar] [CrossRef]
- Cui, G.; Zhang, C.; Wang, A.; Zhou, X.; Xing, X.; Liu, J.; Li, Z.; Chen, Q.; Lu, Q. Research progress on self-healing polymer/graphene anticorrosion coatings. Prog. Org. Coat. 2021, 155, 106231. [Google Scholar] [CrossRef]
- Chen, J.; Shi, X.; Qi, S.; Mohai, M.; Bertóti, I.; Gao, Y.; Dong, H. Reducing and multiple-element doping of graphene oxide using active screen plasma treatments. Carbon 2015, 95, 338–346. [Google Scholar] [CrossRef]
- Xu, G.; Deng, C.; Xing, L.; Hu, J. Preparation and properties of siloxane-modified styrene-acrylate latex particles with core-shell structure. Int. J. Polym. Mater. Polym. Biomater. 2013, 62, 488–492. [Google Scholar] [CrossRef]
- Lei, H.; He, D.; Guo, Y.; Tang, Y.; Huang, H. Synthesis and characterization of UV-absorbing fluorine-silicone acrylic resin polymer. Appl. Surf. Sci. 2018, 442, 71–77. [Google Scholar] [CrossRef]
- Wu, Y.; Wen, S.; Chen, K.; Wang, J.; Wang, G.; Sun, K. Enhanced corrosion resistance of waterborne polyurethane containing sulfonated graphene/zinc phosphate composites. Prog. Org. Coat. 2019, 132, 409–416. [Google Scholar] [CrossRef]
- Keshmiri, N.; Najmi, P.; Ramezanzadeh, B.; Ramezanzadeh, M.; Bahlakeh, G. Nano-scale P, Zn-codoped reduced-graphene oxide incorporated epoxy composite; synthesis, electronic-level DFT-D modeling, and anti-corrosion properties. Prog. Org. Coat. 2021, 159, 106416. [Google Scholar] [CrossRef]
- Jindal, R.; Raja, V.; Gibson, M.A.; Styles, M.J.; Bastow, T.J.; Hutchinson, C. Effect of annealing below the crystallization temperature on the corrosion behavior of Al–Ni–Y metallic glasses. Corros. Sci. 2014, 84, 54–65. [Google Scholar] [CrossRef]
- Kumar, A.; Nayak, S.K.; Sarkar, K.; Banerjee, A.; Mondal, K.; Laha, T. Investigation of nano-and micro-scale structural evolution and resulting corrosion resistance in plasma sprayed Fe-based (Fe-Cr-BCP) amorphous coatings. Surf. Coat. Technol. 2020, 397, 126058. [Google Scholar] [CrossRef]
- Mansfeld, F.; Kendig, M. Evaluation of anodized aluminum surfaces with electrochemical impedance spectroscopy. J. Electrochem. Soc. 1988, 135, 828. [Google Scholar] [CrossRef]
- Hitzig, J.; Jüttner, K.; Lorenz, W.J.; Paatsch, W. AC-Impedance measurements on corroded porous aluminum oxide films. J. Electrochem. Soc. 1986, 133, 887. [Google Scholar] [CrossRef]
- Chung, S.; Cheng, J.; Chiou, S.; Shih, H. EIS behavior of anodized zinc in chloride environments. Corros. Sci. 2000, 42, 1249–1268. [Google Scholar] [CrossRef]
- Liu, H.; Gu, T.; Zhang, G.; Cheng, Y.; Wang, H.; Liu, H. The effect of magneticfield on biomineralization and corrosion behavior of carbon steel induced by iron-oxidizing bacteria. Corros. Sci. 2016, 102, 93–102. [Google Scholar] [CrossRef]
- Yang, Y.; Zhang, C.; Peng, Y.; Yu, Y.; Liu, L. Effects of crystallization on the corrosion resistance of Fe-based amorphous coatings. Corros. Sci. 2012, 59, 10–19. [Google Scholar]
- Liu, C.; Bi, Q.; Leyland, A.; Matthews, A. An electrochemical impedance spectroscopy study of the corrosion behaviour of PVD coated steels in 0.5 N NaCl aqueous solution: Part II.: EIS interpretation of corrosion behaviour. Corros. Sci. 2003, 45, 1257–1273. [Google Scholar]
- Guo, R.Q.; Zhang, C.; Chen, Q.; Yang, Y.; Li, N.; Liu, L. Study of structure and corrosion resistance of Fe-based amorphous coatings prepared by HVAF and HVOF. Corros. Sci. 2011, 53, 2351–2356. [Google Scholar] [CrossRef]
- Du, F.; Jin, Z.; She, W.; Xiong, C.; Feng, G.; Fan, J. Chloride ions migration and induced reinforcement corrosion in concrete with cracks: A comparative study of current acceleration and natural marine exposure. Constr. Build. Mater. 2020, 263, 120099. [Google Scholar] [CrossRef]
- Zhang, C.; Chan, K.C.; Wu, Y.; Liu, L. Pitting initiation in Fe-based amorphous coatings. Acta Mater. 2012, 60, 4152–4159. [Google Scholar] [CrossRef]
- Sarac, I.; Adin, H.; Temiz, S. Experimental determination of the static and fatigue strength of the adhesive joints bonded by epoxy adhesive including different particles. Composites 2018, 155B, 92–103. [Google Scholar] [CrossRef]
- Wei, H.; Xia, J.; Zhou, W.; Zhou, L.; Ostrikov, K.K. Adhesion and cohesion of epoxy-based industrial composite coatings. Compos. Part B Eng. 2020, 193, 108035. [Google Scholar] [CrossRef]

| Element | Fe | Cr | Mo | C | B |
|---|---|---|---|---|---|
| Content (at%) | 47.6 | 23.5 | 10.0 | 14.2 | 4.7 |
| Sample | |
|---|---|
| 0# | Fe-based amorphous coating (unsealed coating) |
| WFE (WFS-0) | Waterborne acrylic sealant (nanofiller content: 0‰) |
| WFS-0.3‰ | Graphene modified waterborne acrylic sealant (nanofiller content: 0.3‰) |
| WFS-1‰ | Graphene modified waterborne acrylic sealant (nanofiller content: 1‰) |
| WFS-3‰ | Graphene modified waterborne acrylic sealant (nanofiller content: 3‰) |
Disclaimer/Publisher’s Note: The statements, opinions and data contained in all publications are solely those of the individual author(s) and contributor(s) and not of MDPI and/or the editor(s). MDPI and/or the editor(s) disclaim responsibility for any injury to people or property resulting from any ideas, methods, instructions or products referred to in the content. |
© 2025 by the authors. Licensee MDPI, Basel, Switzerland. This article is an open access article distributed under the terms and conditions of the Creative Commons Attribution (CC BY) license (https://creativecommons.org/licenses/by/4.0/).
Share and Cite
Wang, G.; Jiang, Y.; Zhou, Z.; Sun, J.; Cheng, Y.; Zhang, S.; Tang, Y. Preparation and Corrosion Resistance Research of Eco-Friendly Strong Penetration Sealant for Fe-Based Amorphous Coatings. Coatings 2025, 15, 623. https://doi.org/10.3390/coatings15060623
Wang G, Jiang Y, Zhou Z, Sun J, Cheng Y, Zhang S, Tang Y. Preparation and Corrosion Resistance Research of Eco-Friendly Strong Penetration Sealant for Fe-Based Amorphous Coatings. Coatings. 2025; 15(6):623. https://doi.org/10.3390/coatings15060623
Chicago/Turabian StyleWang, Guangyu, Yinfang Jiang, Zehua Zhou, Jianhua Sun, Yang Cheng, Shenghua Zhang, and Yuzhi Tang. 2025. "Preparation and Corrosion Resistance Research of Eco-Friendly Strong Penetration Sealant for Fe-Based Amorphous Coatings" Coatings 15, no. 6: 623. https://doi.org/10.3390/coatings15060623
APA StyleWang, G., Jiang, Y., Zhou, Z., Sun, J., Cheng, Y., Zhang, S., & Tang, Y. (2025). Preparation and Corrosion Resistance Research of Eco-Friendly Strong Penetration Sealant for Fe-Based Amorphous Coatings. Coatings, 15(6), 623. https://doi.org/10.3390/coatings15060623
